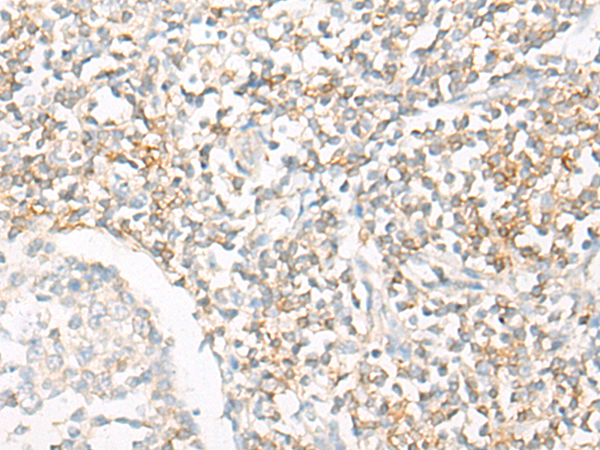

|
Background: |
The protein encoded by this gene is a pleiotropic cytokine that functions as a chemoattractant, a modulator of T cell activation, and an inhibitor of HIV replication. The signaling process of this cytokine is mediated by CD4. The product of this gene undergoes proteolytic processing, which is found to yield two functional proteins. The cytokine function is exclusively attributed to the secreted C-terminal peptide, while the N-terminal product may play a role in cell cycle control. Caspase 3 is reported to be involved in the proteolytic processing of this protein. Alternate splicing results in multiple transcript variants. |
|
Applications: |
ELISA, IHC |
|
Name of antibody: |
IL16 |
|
Immunogen: |
Synthetic peptide corresponding to a region derived from 1318-1332 amino acids of human IL16 |
|
Full name: |
interleukin 16 |
|
Synonyms: |
LCF; NIL16; PRIL16; prIL-16 |
|
SwissProt: |
Q14005 |
|
ELISA Recommended dilution: |
5000-10000 |
|
IHC Positive control: |
Human liver cancer;Human tonsil |
|
IHC Recommended dilution: |
20-100 |

購物車
幫助
021-54845833/15800441009
